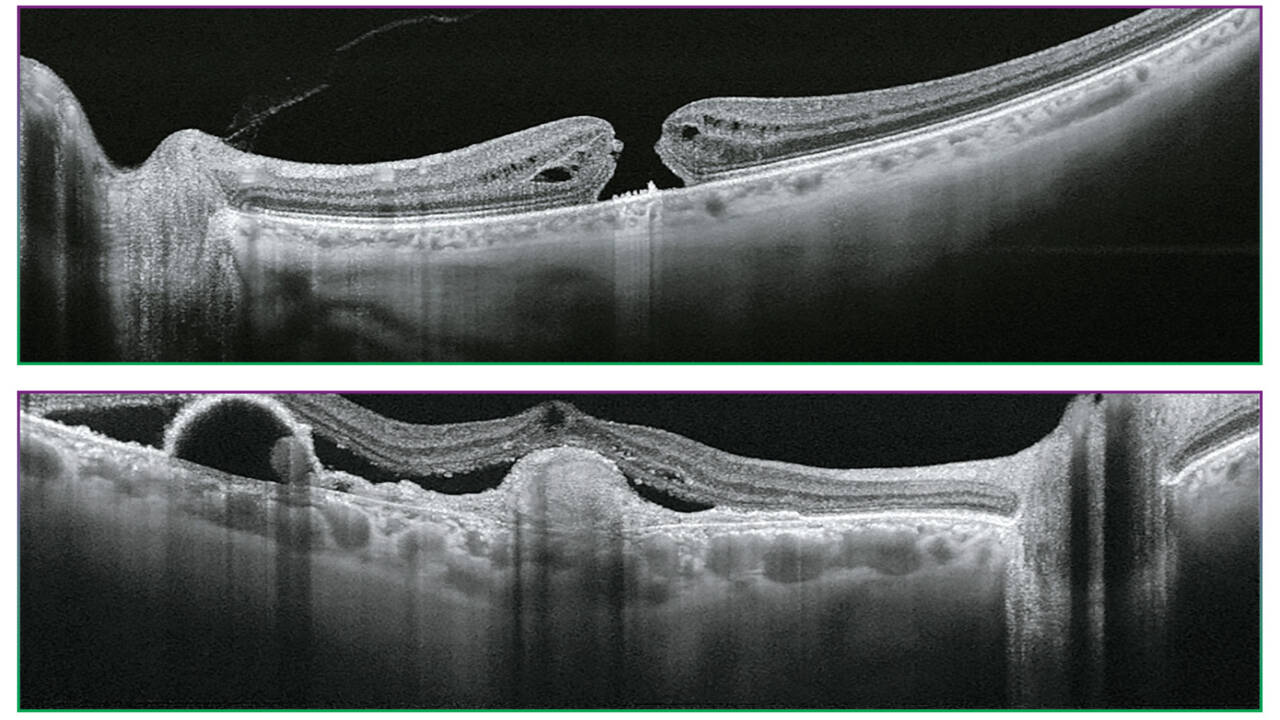

Topcon TRITON /TRITON PLUS
DRI OCT Triton, dünyanın ilk Swept Source OCT teknolojisini multimodal fundus görüntüleme ile birleştirir.
Triton
Temel özellikler
100.000 A-tarama/sn tarama hızına sahip Swept-Source OCT
1050 nm dalga boyu
Multimodal görüntüleme: Gerçek Renkli Fundus Fotoğrafçılığı, OCT-Anjiyografi(1), OCT ve OCT-A(1) için Geniş Alan, Ön Segment(1), FA*, FAF*
Описание
Görüntü Kalitesi
Triton’un 100 kHz tarama hızı ve 1.050 nm dalga boyuna sahip Swept Source OCT teknolojisi, kısa görüntü alma süresiyle gözün en derin katmanları için bile net ve ayrıntılı görüntüler sağlar. Sadece retina ve vitreus değil, koroid ve sklera da görüntülenebilir2.
YENİ: OCT ve OCT-A1’de artefaktları azaltan ve kontrastı artıran Topcon’un benzersiz AI algoritması Smart Denoise1’i keşfedin.
Teşhis yeteneği
Daha derinlemesine görme, birçok oküler patolojiyi2 daha iyi anlamayı mümkün kılar. OCT Anjiyografi1, Fundus Otofloresans* ve En Face OCT gibi özelliklerle Triton, klinisyenlere hastanın göz sağlığını değerlendirmeye ve korumaya yardımcı olacak multimodal görüntüleme yeteneği sunar.
Uygulama verimliliği
Tek tarama yakalama ve SMARTTrackTM sistemi dahil olmak üzere Triton’un otomatik işlevleri, veri yakalama, analiz ve takibi basitleştirerek uygulama iş akışınızı optimize etmek için tasarlanmıştır.

Courtesy: Professor Jose Maria Ruiz Moreno MD, University of Albacete, Spain
Swept Source OCT GÖRÜNTÜLEME
1.050 nm dalga boyu
Daha uzun dalga boylu ışık, dokuya daha iyi nüfuz ederek gözün en derin katmanlarının görüntülenmesini sağlar2.
Swept Source OCT teknolojisi ve 100.000 A-tarama/saniye tarama hızı
100.000 A-tarama/sn’lik hızlı tarama hızı, belirli bir görüntü alma süresi içinde daha fazla A-tarama elde ederek net B-tarama’larin yakalanmasını sağlar. Bu, sakadlar ve göz kırpmaları gibi istemsiz göz hareketlerinden kaynaklanan artefaktları azaltmaya yardımcı olur.
Görünmez tarama çizgileri
Görünmez 1.050 nm dalga boyundaki ışık, hastaların tarama sırasında sabitleme hedefine odaklanmalarına yardımcı olarak istemsiz göz hareketlerini azaltır. Yeniden tarama ihtiyacını azaltarak muayenehanede daha verimli bir iş akışını destekler.
Swept Source OCT, multimodal fundus görüntüleme özelliğini içerir.
True Colour Fundus görüntüleri
DRI OCT Triton, gerçek renkli, midriyatik olmayan fundus görüntüsü sunar. Triton Plus’ın tanı yeteneğini geliştirmek için Floresan Anjiyografi (FA)* ve Fundus Otofluoresans (FAF)* kullanılabilir.
Hepsi bir arada cihaz, pratikte verimli iş akışını destekler. Swept Source OCT, multimodal fundus görüntülemesini içerir. DRI OCT Triton, tek bir çekimde OCT ve fundus görüntüsünü elde edebilir.
PinPoint™ Kayıt, fundus görüntüsünde B-taramanın konumunu belirler. B-tarama ve fundus görüntüsü arasındaki karşılaştırma, tanı sırasında klinik verimliliği destekleyebilir.
YENİ: Geniş Alan OCT ve OCT-A
İsteğe bağlı Geniş Alan ek lens, 21 mm uzunluğa kadar taramaların yakalanmasını sağlar. OCT ve OCT-A görselleştirme ile daha fazla klinik bilgi edinin. Geniş Alan görüntüleme, çok çeşitli durumlarda değerlidir.


YENİ: Ön Segment Ölçümleri
Triton’un isteğe bağlı ön segment görüntüleme özellikleri, kornea, ön kamara açısı, iris ve ön skleranın görüntülenmesini sağlar ve kantitatif analizi entegre eder.
Yeni ön segment özelliği, ayrıntılı raporlarla Triton’un göz bakım ortamlarındaki değerini yeniden teyit eder.


Takip Fonksiyonu
Bu işlev, geçmiş ve mevcut görüntüleri karşılaştırmak için takip sırasında aynı konumu geri çağırmanıza ve yeniden analiz etmenize olanak tanır. Operatörün tek yapması gereken geçmiş verileri seçmek; Triton aynı alanı otomatik olarak yakalar.

Daha fazla olasılığı keşfedin: daha ötesini ve daha derini görün
SS-OCT Anjiyografi
Topcon’un SS-OCT Angio™ ürünü, OCT anjiyografiyi Swept-Source teknolojisiyle birleştirir.
Tescilli bir görüntü işleme algoritması olan OCTARA™, yüksek hassasiyetli anjiyografik algılama4 sağlayarak, koroid ve daha derin retina katmanlarında bile vasküler yapıların görselleştirilmesine olanak tanır.

OCTARATM
OCTARATM, aynı konumda elde edilen çoklu OCT B-Tarama görüntülerini kullanarak vasküler akıştan kaynaklanan sinyal değişikliklerini çıkaran görüntü işleme teknolojisidir. Mikro damarlardaki düşük kan akışını tespit etmede yüksek hassasiyet gösterir
Yüksek hassasiyetli görüntüleme ve daha derin intravasküler akış görselleştirme1
Swept Source teknolojisi ve OCTARA™, daha derin yapıların daha az derinlik bağımlı sinyal düşüşüyle görselleştirilmesini sağlar3. Ayrıca, 1μm dalga boyu, medya opasiteleri olan hastalar için OCT Anjiyografi görüntülemesini mümkün kılar.
Hızlı Tarama, Gerçek Zamanlı Göz Takibi
Saniyede 100.000 A-Tarama, görünmez tarama çizgileri ve SMARTTrack™ göz takip sistemi ile Triton, yoğun bir veri setini hızla yakalar ve retina mikrovasküler akış ağının En Face OCT Anjiyografi görüntüsünü sunar.

* Yalnızca DRI OCT Triton Plus
1) İsteğe bağlı ekstra
2) Fabio Lavinsky, Daniel Lavinsky. Süpürülmüş kaynaklı optik koherens tomografiye yeni bakış açıları. Int J Retin Vitr (2016) 2:25
3) Shoji Kishi. Süpürme kaynağı optik koherens tomografinin oftalmolojiye etkisi. Taiwan Journal of Ophthalmology 6 (2016) 58-68
4) Magdy Moussa, Mahmoud Leila, Hagar Khalid. En face süpürme kaynağı optik koherens tomografi anjiyografi kullanarak koroidal neovasküler membranın görüntülenmesi.
Klinik Oftalmoloji 2017:11 1859–1869
5) OCT Anjiyografi tarama çizgisi, belirli durumlarda bazı kişiler tarafından çekim sırasında hafifçe görülebilir
6) Beyaz ışıkla 24 bit renkli renkli fundus görüntüsü
Tüm ürünler, hizmetler veya teklifler her pazarda onaylanmış veya sunulmuş değildir ve ürünler ülkeden ülkeye farklılık gösterir. Ülkeye özgü bilgiler için yerel distribütörünüzle iletişime geçin.
Ürün, tıbbi cihazlara ilişkin 2017/745 sayılı AB Yönetmeliği (MDR) ile uyumludur.

